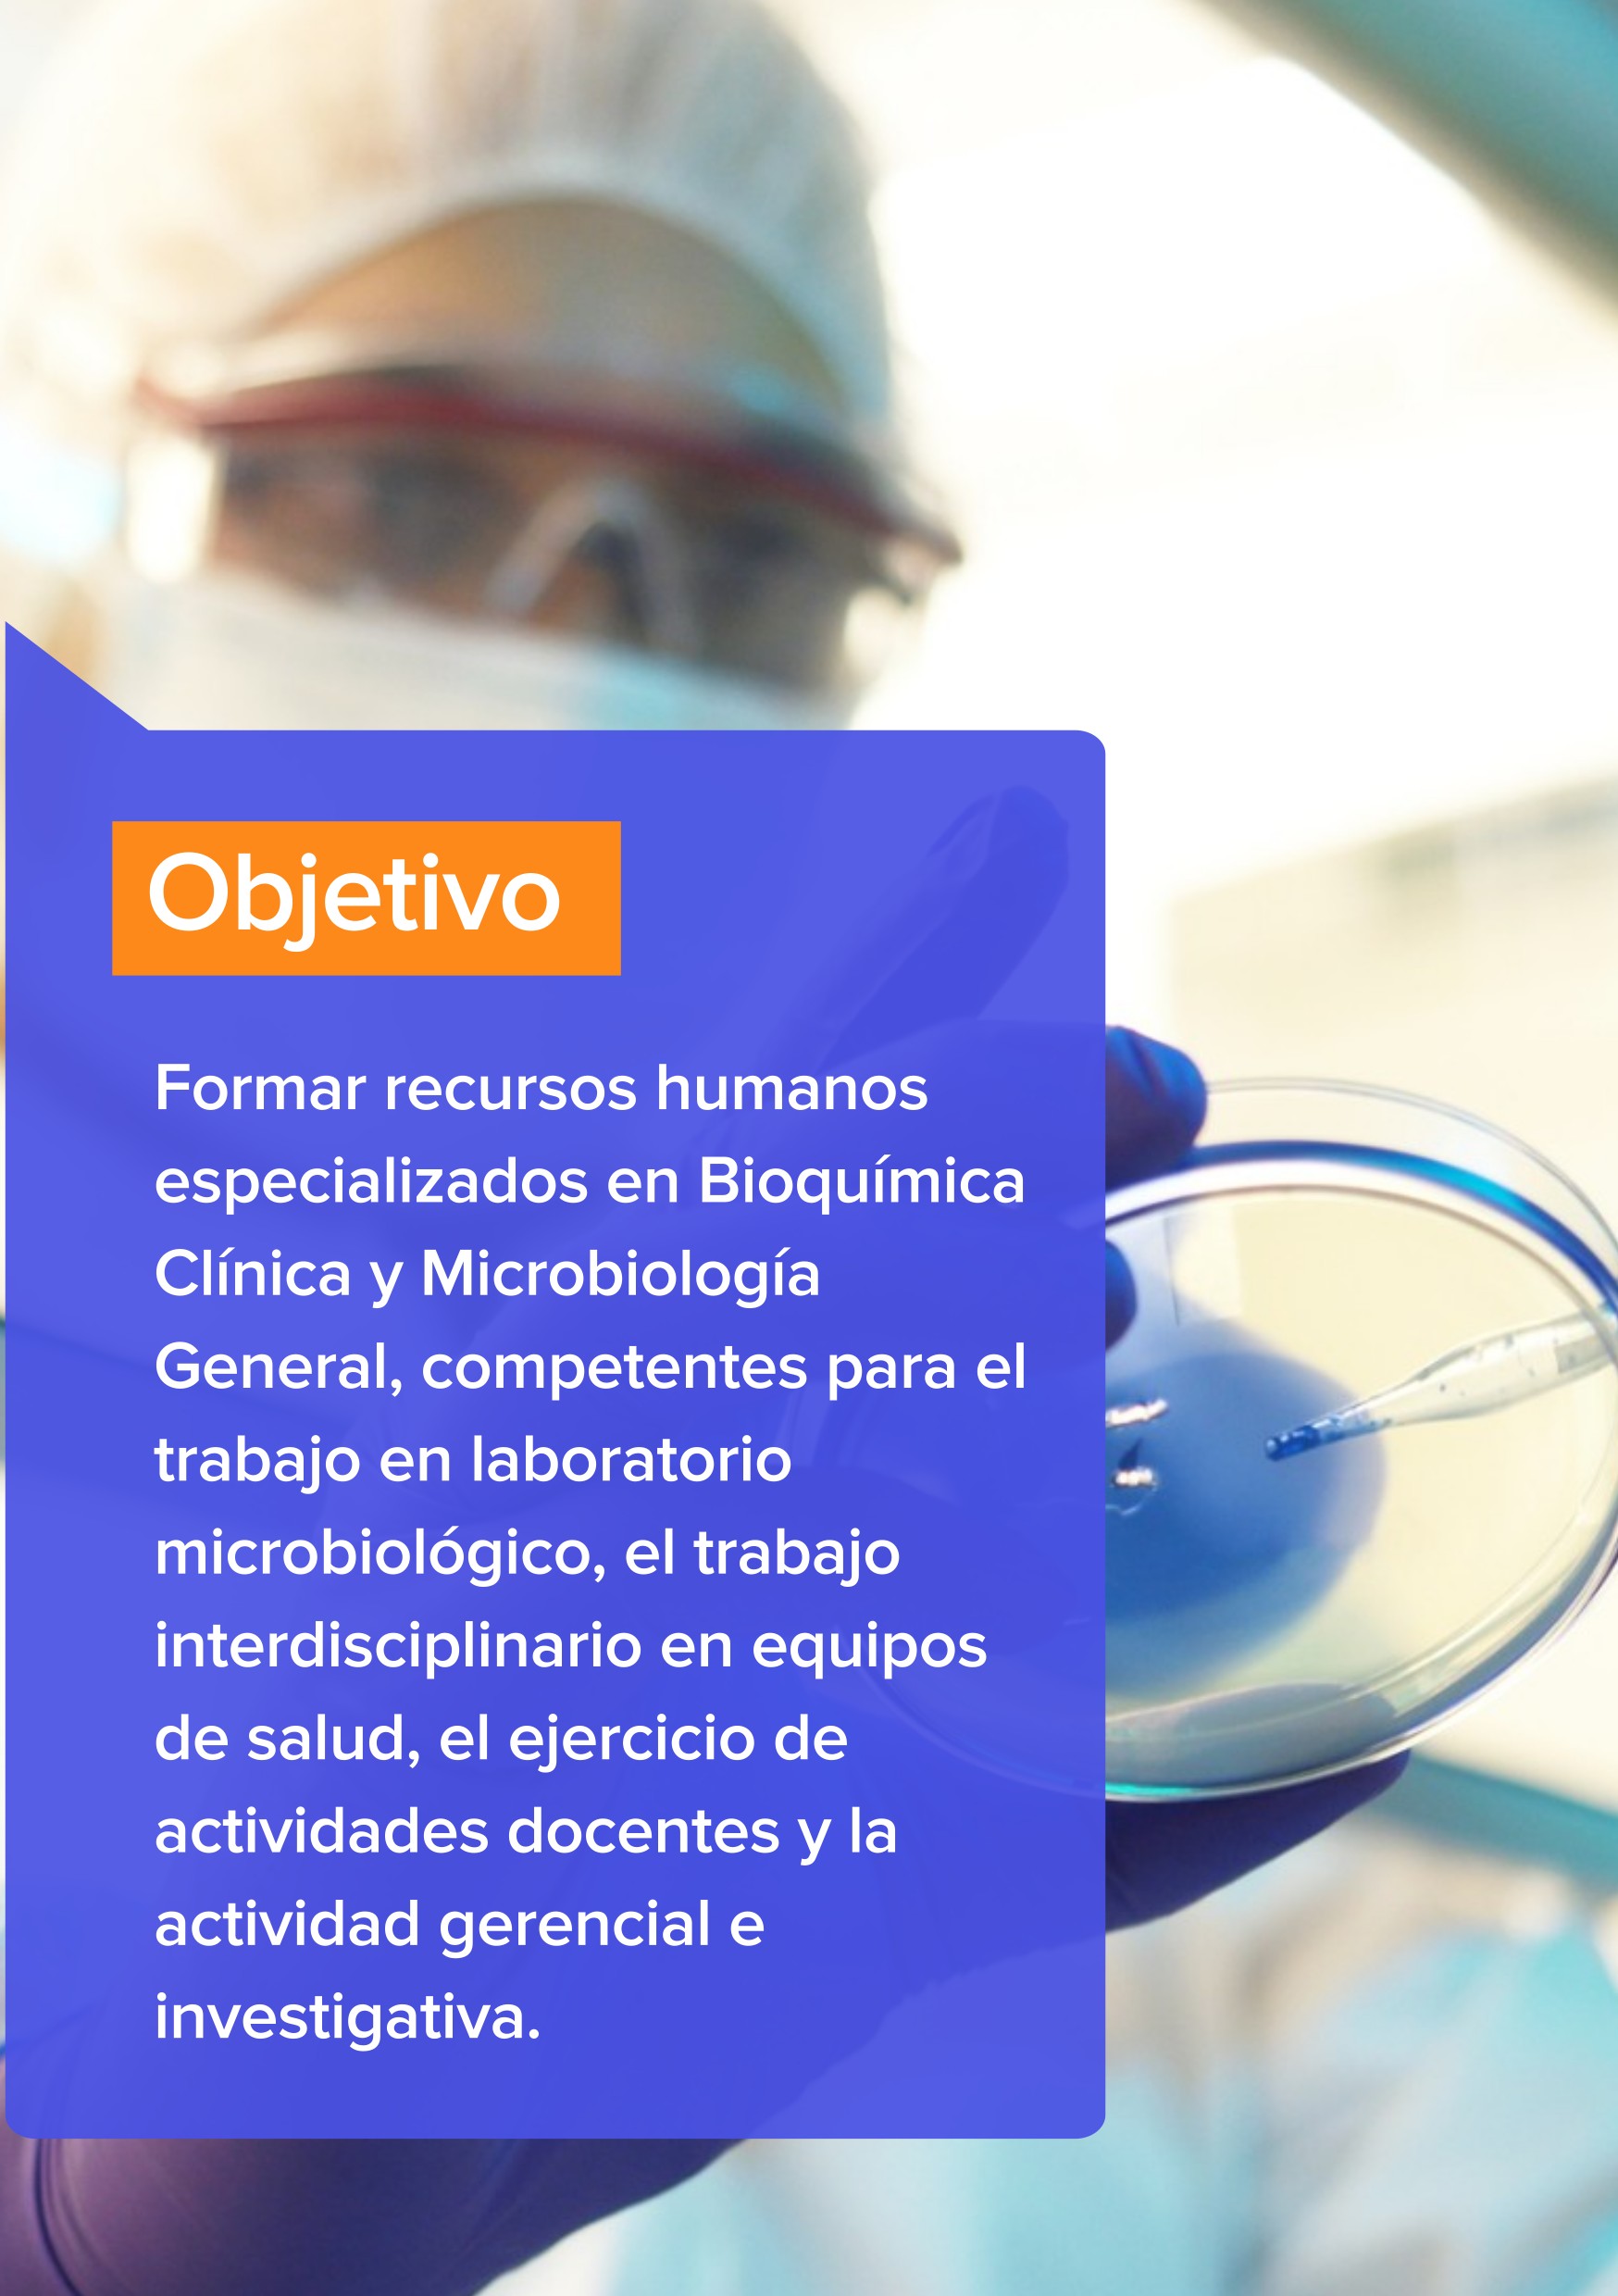

Comparte esto:
- Enviar un enlace a un amigo por correo electrónico (Se abre en una ventana nueva) Correo electrónico
- Comparte en Facebook (Se abre en una ventana nueva) Facebook
- Imprimir (Se abre en una ventana nueva) Imprimir
- Compartir en X (Se abre en una ventana nueva) X
- Compartir en WhatsApp (Se abre en una ventana nueva) WhatsApp
